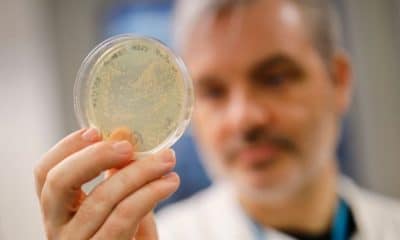
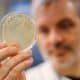

El Ministerio de Sanidad va a recopilar los datos personales de aquellos que decidan no vacunarse del coronavirus. Esta decisión ha despertado dudas sobre su legalidad y sobre...



La Demanda Criminal interpuesta contra el cargo electo del Gobierno de España, para el Centro de Coordinación de Alertas y Emergencias Sanitarias, y funcionario de la...



La investigación de IrsiCaixa y el Dentaid Research Center se centra ahora en la eficacia del cloruro de cetilpiridino en humanos. Este descubrimiento puede ser muy importante...

Al menos un caso de la nueva variante supuestamente más contagiosa del virus del PCCh (Partido Comunista Chino), también conocido como nuevo coronavirus, ha sido detectado en...



El escándalo, sea por las razones que fuere, está tomando dimensiones estratosféricas. Y como es natural, la confianza de los ciudadanos está cayendo a toda velocidad,...



En un artículo sobre el lanzamiento de la vacuna COVID, CNN dice que los estadounidenses no deben alarmarse si la gente comienza a morir después de ponerse...



En Cánada, ha ocurrido un hecho increíble. Una mujer decidió acabar con su vida por aburrimiento haciendo uso de la Ley de Eutanasia. Aunque para que...



De la misma manera que Alemania fue condenada a costear las reparaciones de la I, y posteriormente, la II Guerra Mundial (II GM), podríamos plantear una...



1-¿Son seguras y eficaces las tradicionales vacunas incluidas actualmente en el calendario vacunal? Sí. Las vacunas de la polio, sarampión, rubeola, meningococo, neumococo, tétanos, difteria, etc…...



La farmacéutica estadounidense Moderna ha puesto precio a su vacuna contra el coronavirus. La compañía ha anunciado que cobrará entre 21 y 31 euros a los gobiernos de todo el mundo por cada...